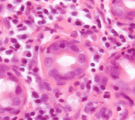

内視鏡 3-a リンパ球プラズマ細胞性十二指腸炎の猫の1例
| 雑種猫、メス、11歳7ヶ月。体重3.26kg。最近1年間、2−3日に1回嘔吐が続いている。食塊または茶色液を吐く、とのことで来院。 | |||
 |
 |
 |
|
| 上腹部X線所見。特異所見なく、原因を確定できなかった。 | 内視鏡所見。胃底部、胃角、幽門部に異常なかった。 | 十二指腸内の内視鏡所見。粘膜の滑沢なく、粗造を呈していた。 | 十二指腸粘膜組織。形質細胞を主体とする顕著な炎症細胞浸潤。 |
| 経過:T:38.3℃、P:148/分、R:40/分。室内外自由。ワクチンは幼少時のみで以降10年間接種なし。同居動物なし。食欲あり。右前額部に15mm×12mmの柔らかい結節あり肥満細胞腫と診断済み。中等度の脱水(BUN 53.1mg/dl)と高Na血症(166 meq/L)あり慢性嘔吐の影響と考えられた。FeLV(-)、FIV(-)。触診にて圧痛、マスなし。上腹部X線でも特異所見なく、精査のため上部消化器内視鏡検査を行なった。胃内に異物、粘膜異常、隆起病変なかったが、十二指腸粘膜に滑沢消失・粗造感が認められた。十二指腸粘膜の内視鏡下生検にて、粘膜固有層に形質細胞を主体とした顕著な炎症細胞浸潤が認められ、リンパ球プラズマ細胞性腸炎と病理診断された。食事内容に注意し、食後嘔吐みられたものを除外していった。市販ドライフードは嘔吐がみられるので中止した。その結果、タラと豚肉なら嘔吐がないことが判明した。 | |||
| コメント:リンパ球プラズマ細胞性十二指腸炎は慢性嘔吐の原因として比較的多くみられる疾患のひとつです。内視鏡下で観察し、生検にて確定診断されます。アレルギー反応と考えられるので、治療はまずアレルゲンの除外を行なっていきます。 | |||